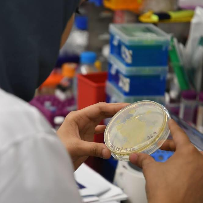
Profile picture

Wiam Alsharif
Masters
-
Doctorate Student / Research AssistantKing Abdullah University of Science and TechnologyThuwal, Saudi Arabia
